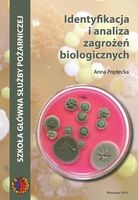

Identyfikacja i analiza zagrożeń biologicznych
| Autor: | Anna Prędecka |
|---|---|
| Wydawca: | Szkoła Główna Służby Pożarniczej (2014) |
| ISBN: | 978-83-88446-40-5 |
| Autotagi: | druk |
| Źródło opisu: | Biblioteka Główna Akademii Sztuki Wojennej - Katalog księgozbioru |
|
|
|
Wypożycz w bibliotece
Kup
Recenzje